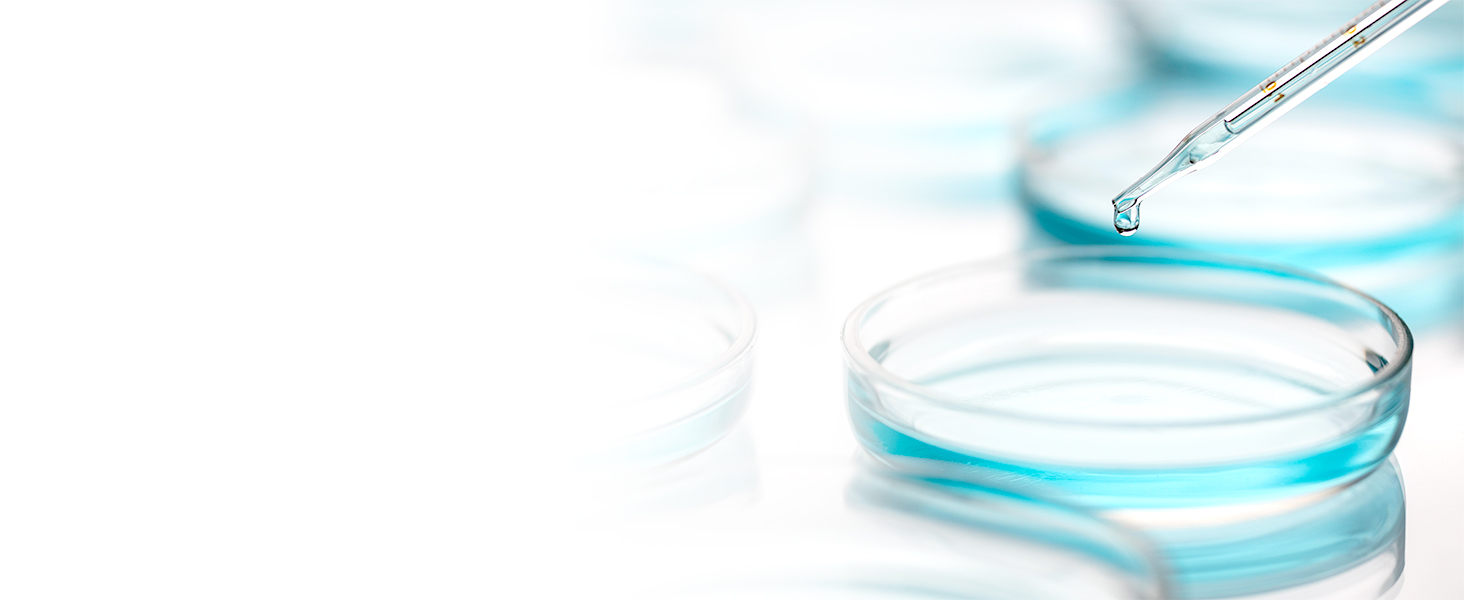
foot mask for dry cracked feet

Product Description






Foot mask with lavender refreshes and soothes. Lavender is known for its aroma and natural qualities.


TOP ingredient when comes to callus removal. It sheds off impurities alongside dead skin cells, maintains your feet skin texture radiant and clean


Malic acid is celebrated for its ability to brighten the skin and smooth its texture, also known as a humectant which helps your skin stay hydrated.


It’s a protective antioxidant with corrective antiaging effects. By exfoliating the upper layer of dead skin cells, it softens and smoothes skin

Masks’ quality and safety is guaranteed by the Independent USA based Global Product Testing Lab.

Our masks were tested on 50 healthy volunteers with 100% positive skin reactions
Our dermatologists created this mask’s formula without any harsh or harmful chemicals
1 Dermatologically approved
2 Hypoallergenic & safe
3 Kind & safe to skin
4 Our Certificate





1 INSTRUCTION 2 EFFECT 3 PAY ATTENTION 4 YOUR FEEDBACK 5 MEDIA APPROVED
LAVINSO MUST HAVE’S
Add to Cart
Add to Cart
Customer Reviews
—
4.3 out of 5 stars
26,012
4.3 out of 5 stars
26,012
4.6 out of 5 stars
1,185
4.6 out of 5 stars
1,185
Price
—
$15.95$15.95
—
$14.95$14.95
—
Apply to
Feet
Feet
Feet
Feet
Feet
Main ingredient
Lavender extract
Peach extract
Aloe Vera
Tea Tree oil
Lavender extract
Solution for
Dry, cracked feet
Deep set calluses
Tough, dead, and callused skin
Foot odor
Athlete’s foot
Effect
Smoothes out rough heels
Rejuvenates skin regeneration
Moisturises and hydrates
Softens & tenderizes your skin
Relieves skin inflammation
Vegan / not tested on animals
✔
✔
✔
✔
✔
HOW LONG DOES PEELING PROCESS TAKE?
Most like a few days. It can take up to a week to remove all the dead skin.
WHEN DOES PEELING PROCESS START?
Dead skin cells will begin to peel 5-7 days after the first application, depending on the rate of renewal of your skin cells. Some people may experience peeling 10-12 days after application.
WILL IT FIT TO A MAN’S FEET?
With our new improved design we took care about it – mask booties are big enough even for large foot.
WHY DO FOOT PEEL MASKS WORK?
Exfoliating acids enter the top layer of skin and break down the bonds that hold skin cells together. A few days after the treatment, bits and pieces (sometimes large swaths) of dead skin flake off your feet.
DOES FOOT PEEL MASK REMOVE CALLUSES?
Absolutely! Within a few days, your old, dead skin will shed to reveal the new skin underneath with no calluses left
Package Dimensions : 7.72 x 5.75 x 0.94 inches; 5.29 ounces
UPC : 850031520066
Manufacturer : Lavinso15 Trading LLC
ASIN : B0B5HJ8VK7
EASY EXFOLIATING: All you have to do is slip your feet into the foot mask socks, leaving on for an hour, and washing away. After application, dead skin will start to peel within 6-11 days. You can get baby soft feet in just one week!
BABY SOFT SMOOTH FEET: In as little as 1-2 weeks, our exfoliating foot peeling mask will soften and tenderize the skin on your feet by removing tough, dead, and callused skin.
POWERFUL BOTANICAL BLEND: Our foot peel mask is made with a combination of fruit acids and extracts that helps to remove dead skin cells from your soles to smooth out rough heels.
ANY SIZE: Our foot exfoliator mask for dry, cracked feet fits feet of most shapes and sizes (up to a men’s size 11), making it perfect gift idea for both men and women.
DERMA TESTED/PAIN FREE: The quality and safety of the foot mask is guaranteed by the Independent USA based Global Product Testing Lab.
foot exfoliator ,






